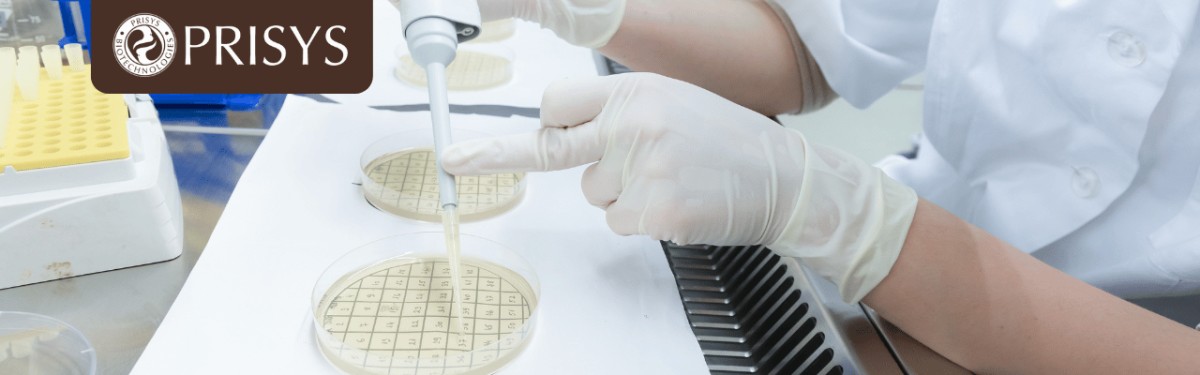
Human Disease Animal Models-2.png Human Disease Animal Models-2.png

动物模型在现代生物医学研究中扮演着不可替代的角色,尤其是在研究人类疾病的机制、发展以及治疗方面。这些模型不仅为科学家们提供了一个探索疾病的实验平台,还帮助他们突破伦理限制,避免人体试验带来的风险。在本博客中,我们将深入探讨人类疾病动物模型的重要性、分类、特点以及它们对科研工作者的意义。
动物模型之所以重要,源于其能够解决临床研究的局限性。对于许多人类疾病,长潜伏期和复杂的病程使得直接在人体上进行试验几乎是不可能的。而动物模型则提供了一个解决方案,它能够通过可控的实验环境和设计来模拟疾病的进展和治疗效果。通过这些模型,研究者能够全面认识疾病的发生发展规律,并且测试各种防治措施的有效性。
比如,动物模型能够复制遗传性、免疫性、代谢性等复杂疾病,并允许研究者通过人为设计的实验条件进行反复观察和研究。这不仅提高了实验结果的可靠性,还避免了人体试验可能带来的道德困境和风险。
根据定义,动物模型是指用于生物医学研究的动物实验对象和相关材料,这些对象能够模拟人类疾病的表现。它们广泛用于实验生理学、实验病理学和实验治疗学研究,尤其在新药筛选过程中发挥了重要作用。
根据不同的研究需求,动物模型可以分为以下几类:
每一种模型的选择都需要经过严格的科学设计和验证,以确保其在实验中能够真实再现人类疾病的特征。
在选择动物模型时,科研人员需要考虑多个因素,以确保实验的有效性。一个优秀的动物模型通常具备以下特点:
再现性:模型能够重复再现人类疾病的核心特征。再现性好的模型能够为研究者提供稳定、可预见的实验结果。
背景资料完整:动物模型的生命周期应满足实验需要,且应有完整的遗传背景资料。背景资料的完整性有助于科学家们更好地理解实验变量对疾病的影响。
专一性:一种方法应专门用于复制一种模型。动物模型不可能完全复制出人类疾病的所有表现,因此应专注于模拟特定的疾病或其特定方面。
可比性与控制性:严格控制实验条件,以提高实验结果的可比性和重复性。例如,在实验中需要对饲养条件、遗传因素、微生物环境和营养等变量进行严密控制,确保实验的精准性。
动物模型为科研人员提供了一个深入理解疾病本质的平台。通过模型,研究者能够对人畜共患病进行比较,揭示同一病原体在不同机体上的表现差异。这样的比较研究有助于科学家们更全面地认识疾病的本质,从而推动疾病治疗和预防措施的发展。
此外,动物模型还能够帮助科研人员开展长期的实验观察,这一点在研究慢性病时尤为重要。例如,某些遗传性或代谢性疾病可能需要经过几代的观察才能得出有意义的结论,而这在人体实验中几乎是不可能实现的。
人类疾病动物模型不仅是生物医学研究中的重要工具,也是推动科学进步的基石。它们帮助研究者克服伦理和时间的限制,提供了一个安全、可控的实验平台。然而,正如我们所看到的,动物模型并非完美,任何模型都不可能完全再现人类疾病的所有特征。因此,科研人员在设计实验时应谨慎选择模型,并根据研究目标做出合理的调整。
总的来说,动物模型的使用不仅为疾病的基础研究提供了强有力的支持,还为新药开发、治疗策略的制定提供了不可或缺的实验依据。对于科研人员来说,了解并合理使用动物模型,将是取得科研成功的关键。
*We respect your confidentiality and all information are protected.